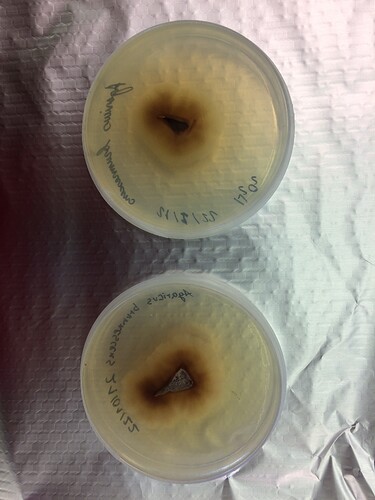

The project I am working on currently was an idea of a friend (Tatek) and colleague at the University of Valladolid. In Cooperation with the Ethiopian environment and forest research institute, which focusses on the exploration and use of NTFP (Non Timer Forest Products), we are looking for possibilities of cultivating edible mushrooms on agricultural waste products. In future, this project shall give oppurtunities to the farmers of ethiopia to integrate this method as a part of circular economy. This project is not directly scientific, but rather focusses on mastering different techniques of mushroom cultivation, in order to develope adequate procedures adapted to the localities and infrastructure of the rural areas in Ethiopia.
state of the art
To give a short insight into our current status, I will shortly explain our key approaches and obstacles:
Since we have a university lab for this purpose, we are working very equipped on most steps of the expansion of mycelial mass. We are currently using Agar-to-grain and grain-to-substrate methods. We have an autoclave, a clean bench, incubaters and a fridge (+cutting tools, bunsen burner etc.).
We are currently working with the species Pleurotus ostreatus, Pleurotus eryngii, Flammulina velutipes, Trametes versicolor, Chondrostereum purpureum, Agaricus bisporus, Agaricus brunnescens and Lentinula edodes. The focus is on edible species over medicinal ones.
For Pleurotus eryngii, Flammulina velutipes, Agaricus bisporus and Agaricus brunnescens we used isolation techniques (with hydrogen peroxide) on specimen bought at the supermarket. The Isolated Agaricus strains seem to suffer from senescence or contamination (I will add pictures).
We are using polypropylen bags and reused preserving jars for the spawn and final substrates. Our fruiting chamber is simply a growing tent.
So far we were succesful of fructificating P. ostreatus and Lentinula edodes for 1-2 flushes. Our contamintation rates are also quite low (of course due to professional equippment).
Spawn and substrates of the other species (exept Agaricus strains) are in progress.
Important challenges to work on
Since we are using several species, substrates and techniques simultaneously, I will specially share with you all the parts of this project that are most challenging, to avoid overloading this thread. If you have any questions, you are very welcome to ask!
Main challenges are:
The fructification without the use of electricity
As most of you most likely already expercienced, there are several factors regarding the environment of a growing chamber, to fullfil the demands of our fungal friends. The maintainance of adequate relative air humidity, air exchanges (oxygen) and light necessary for the primordial and fruiting phase without the use of electricity (in worst case with low electricity needs) are one of our main objectives. So far we are using the growing tent and an aerosol for humidity. It is known that aerosoles are favoring bacterial contamination and the danger of suffocation of primordial formations due to excessive application. Furthermore, we are winding up seeing the water landing on the walls and running down to the floor and our blocks drying out after the first flush. The fruiting bodies of P. ostreatus also seemed pale, probably as a result of insufficient light. If you are aware of techniques that could help us solve this problem, please let us know! ![]()
The sterilization of substrates without autoclave or pressure cooker
This step of the procedure has not been developed yet (we focused on the fructification), but should be elaborated soon (parallel to our other trials). Techniques to try are a three day sequence of boiling the substrate for 30 min each days, giving the spores inside the substrate time to germinate, before heating (and hopefully destroying them) the following day. Another interesting technique uses a several day yeast fermentation to remove unwanted microorganisms. I will share updates on the progress of these methods!
If you are aware of further sterilization techniques, we are happy to hear about it
PS: a picture of our cloned Agaricus strain that looks very sick. It looks moreless like a fluffy mycelium (not sure if visible on picture) with a dark bottom part (almost like a contaminant), growing extremely slow. The hyphae started shooting out of the extracted flesh, which supports our hope that it is not a contaminant. But since no one of us has seen proper Agaricus mycelium before, we are not sure if it is supposed to look like that. Does anyone here know more? ![]()
I will share some more results in the following weeks, keeping you updated!
We are happy about any kind of feedback, question or criticism!